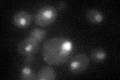
YER048C
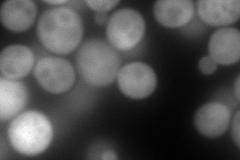
YER048C
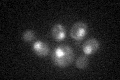
YER048C

View description
Nuclear type II J heat shock protein of the E. coli dnaJ family, contains a leucine zipper-like motif, binds to non-native substrates for presentation to Ssa3p, may function during protein translocation, assembly and disassembly
Localization:
Intensity:
Fold change:
Significance:
-
C’ GFP library in SD
nucleus28.5 -
N' NOP1pr-GFP in SD

cytosol,cell periphery218.178 -
N' TEF2pr-mCherry in SD
cytosol347.442 -
N' NATIVEpr-GFP in SD

cytosol61.8744 -
N' TEF2pr-VC and Cyto-VN in SD

cytosol65.5346 -
C’ GFP library in SD+DTT

nucleus26.670.93No -
C’ GFP library in SD+H2O2
nucleus24.910.87No -
C’ GFP library in Starvation Media

nucleus37.081.3No -
C’ GFP library on the background of Pup2-DaMP

nucleus -
C’ GFP library on the background of CCT mutant

nucleus25.02890.877912No
